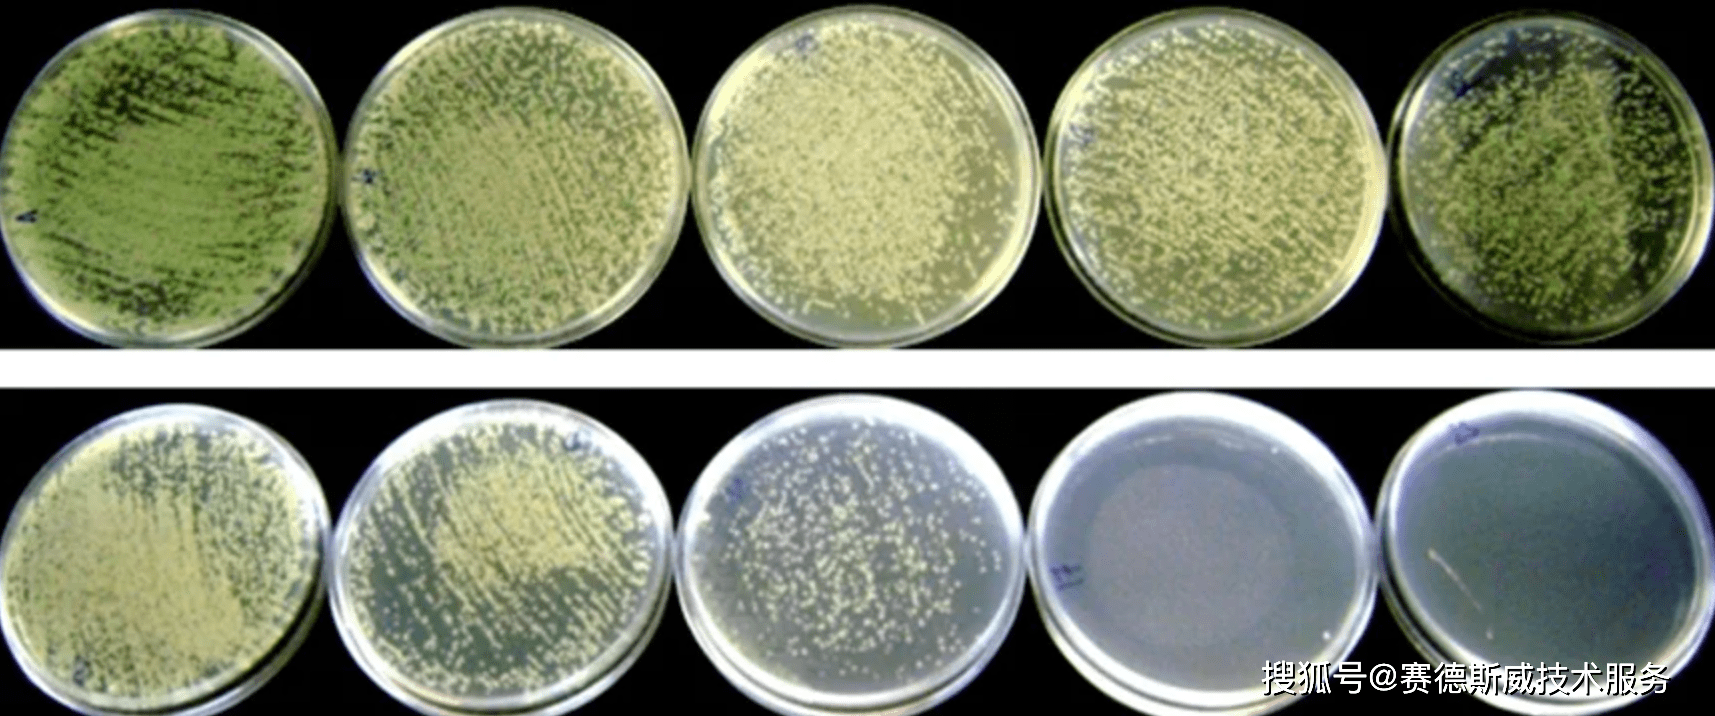
iso274472019瓷砖陶瓷抗菌测试光催化材料抗菌活性试验方法
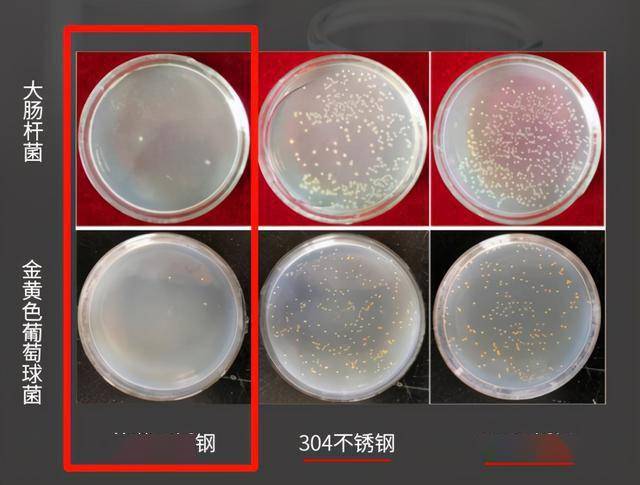
中科院研发专利不锈钢解决传统筷子发霉的问题抗菌防霉又防滑

抑菌实验

【求助】急~~做抑菌试验没有出现抑菌圈的原因
图片尺寸3872x2592
israeli researchers develop method for 30-second b
图片尺寸974x650
iso274472019瓷砖陶瓷抗菌测试光催化材料抗菌活性试验方法
图片尺寸1715x716
抗菌常见检测方法
图片尺寸600x400
纳米胶水对金黄色葡萄球菌(左图)和大肠杆菌(右图)的抑菌圈试验
图片尺寸800x393
检验技能大比拼——职业教育活动周风采展示
图片尺寸1440x1080
抑菌试验
图片尺寸500x375
生孢梭菌cmcc64941标准菌株质量控制抑菌试验菌种北京顺丰直邮
图片尺寸800x800
抑菌环试验
图片尺寸323x240
求助抑菌圈实验
图片尺寸1080x810
食用不当会生病!实验告诉你海产品怎样吃才安全
图片尺寸1080x720
抑菌实验情况对比图与普通木材相比,人们把内衣物放在药木杜仲制成的
图片尺寸685x511
取被试验抑菌样液和对照样液(要求对照样液与被试验样液是同质材料
图片尺寸600x398
中科院研发专利不锈钢解决传统筷子发霉的问题抗菌防霉又防滑
图片尺寸640x485
抑菌圈
图片尺寸2667x2000
抑菌剂效力检测
图片尺寸1998x1406
伊莱特抗菌实验河南省畜牧研究所图
图片尺寸1124x811
抑菌圈演示测试图片
图片尺寸456x452
抑菌试验的介绍
图片尺寸450x305
【求助】求抑菌圈实验指导
图片尺寸750x750